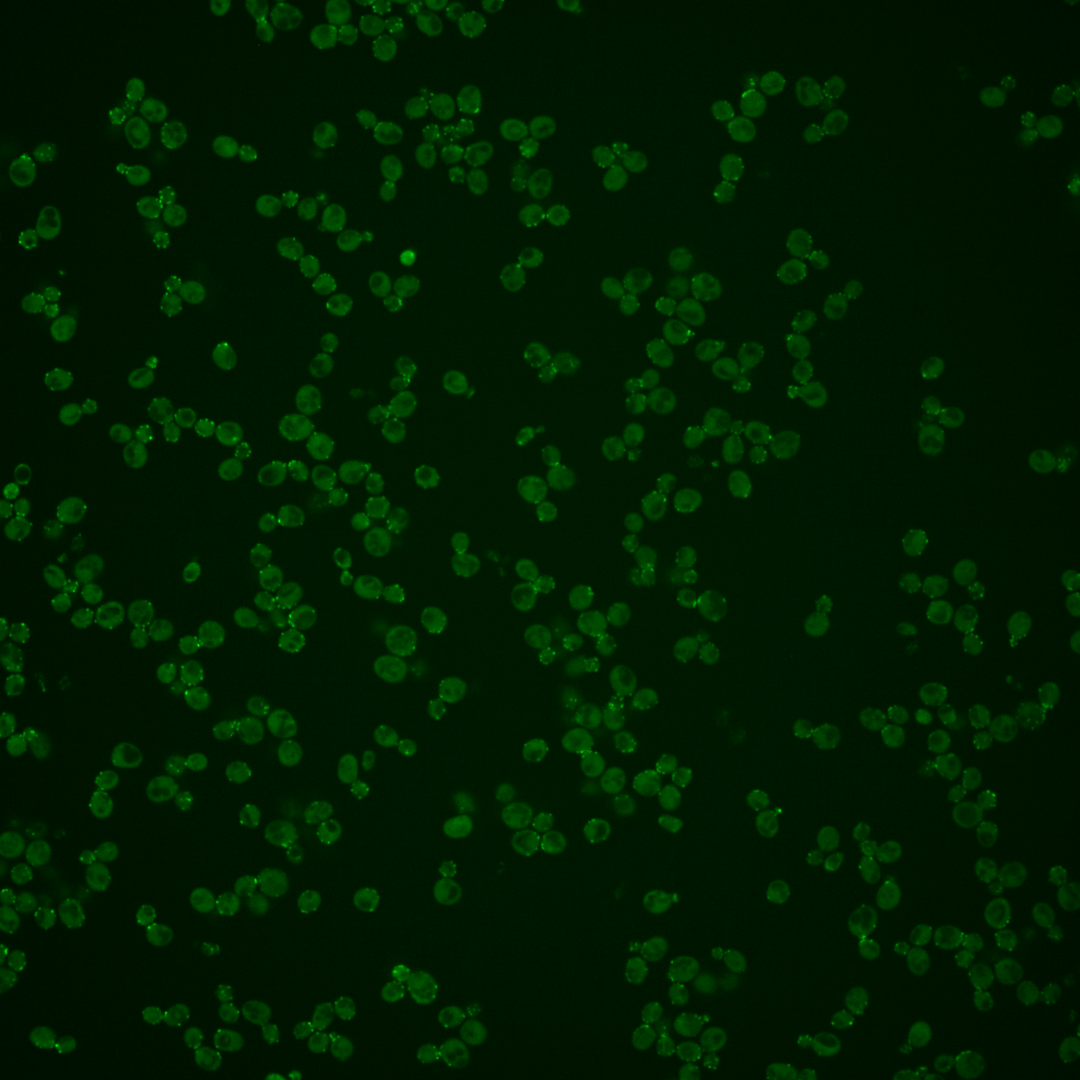
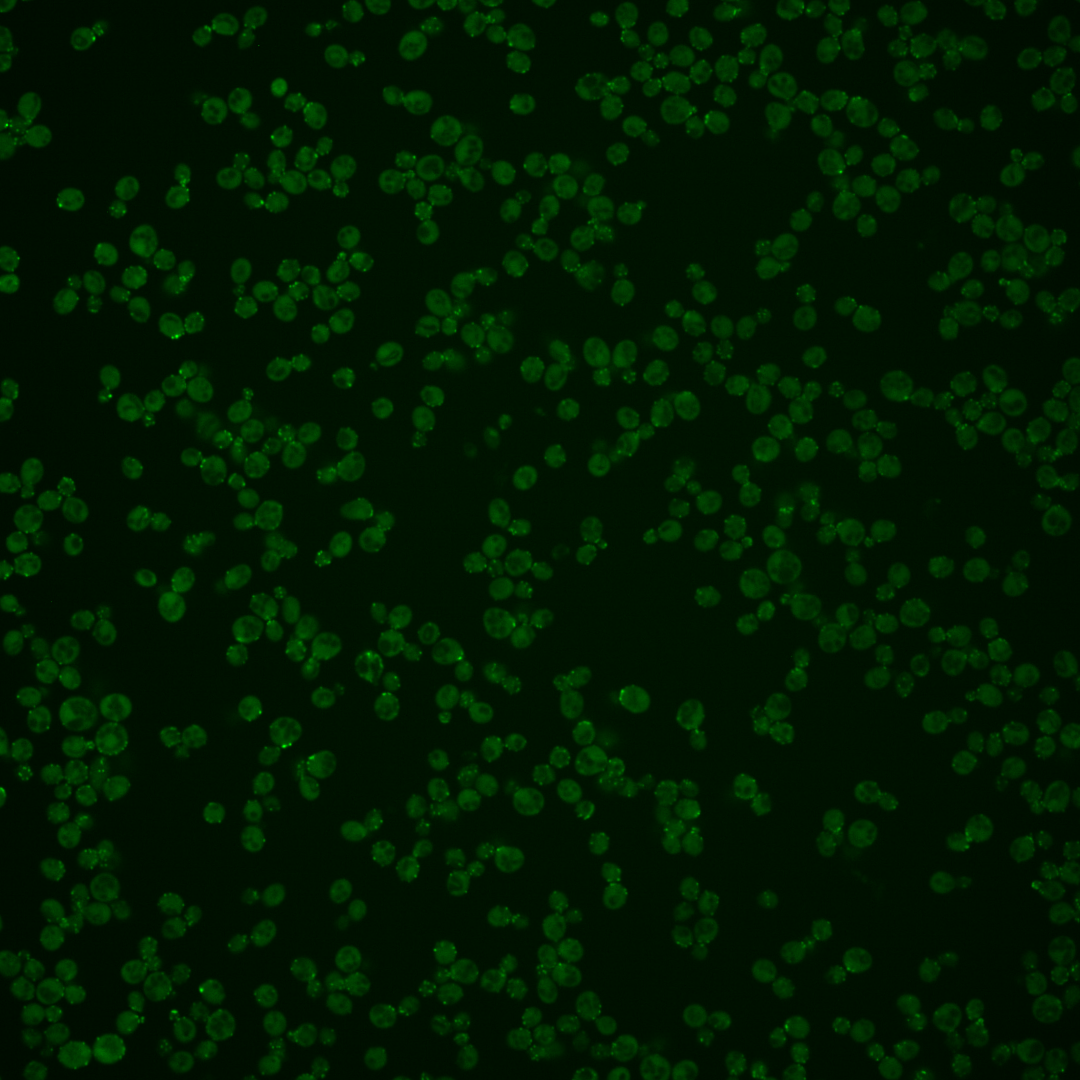

| Standard name | |
|---|---|
| Human Ortholog | |
| Description | Subunit of a complex that associates with actin filaments; forms a complex with Tda2p that inhibits barbed end F-actin assembly; elevates actin monomer pools to increase endocytotic efficiency and to regulate the distribution of actin between cables and patches; Aim21p/Tda2p forms a larger complex with actin capping proteins Cap1p and Cap2p; involved in mitochondrial migration along actin filaments; recruited to cortical actin patches by SH3 domain-containing proteins Bbc1p and Abp1p |
Micrographs




















































































Sub-cellular Localization
Yeast GFP Assignment
Protein Abundance
Localization Change
External localization resources
| ensLOC | DeepLoc | |||||||||||||||||||||||
|---|---|---|---|---|---|---|---|---|---|---|---|---|---|---|---|---|---|---|---|---|---|---|---|---|
| Localization | WT1 | WT2 | WT3 | RAP60 | RAP140 | RAP220 | RAP300 | RAP380 | RAP460 | RAP540 | RAP620 | RAP700 | HU80 | HU120 | HU160 | rpd3Δ_1 | rpd3Δ_2 | rpd3Δ_3 | WT1 | WT2 | WT3 | AF100 | AF140 | AF180 |
| Cortical Patches | 191 | 138 | 67 | 80 | 74 | 120 | 107 | 119 | 35 | 77 | 29 | 76 | 143 | 172 | 158 | – | – | – | 240 | 179 | 87 | 137 | 240 | 296 |
| Bud | 48 | 33 | 11 | 24 | 22 | 28 | 36 | 37 | 12 | 35 | 16 | 19 | 31 | 34 | 32 | – | – | – | 18 | 10 | 5 | 25 | 45 | 39 |
| Bud Neck | 0 | 0 | 1 | 0 | 0 | 0 | 0 | 0 | 0 | 0 | 0 | 0 | 0 | 0 | 0 | – | – | – | 7 | 10 | 7 | 21 | 26 | 26 |
| Bud Site | 16 | 2 | 1 | 4 | 4 | 6 | 5 | 5 | 0 | 3 | 0 | 4 | 5 | 4 | 0 | – | – | – | – | – | – | – | – | – |
| Cell Periphery | 21 | 20 | 9 | 9 | 13 | 23 | 14 | 16 | 1 | 18 | 4 | 5 | 22 | 47 | 42 | – | – | – | 0 | 1 | 1 | 0 | 1 | 2 |
| Cytoplasm | 50 | 35 | 22 | 15 | 43 | 23 | 38 | 54 | 13 | 28 | 17 | 15 | 53 | 53 | 93 | – | – | – | 12 | 17 | 5 | 12 | 13 | 31 |
| Endoplasmic Reticulum | 30 | 26 | 11 | 12 | 11 | 35 | 54 | 42 | 20 | 25 | 17 | 29 | 24 | 33 | 47 | – | – | – | 2 | 2 | 3 | 1 | 4 | 7 |
| Endosome | 1 | 9 | 5 | 6 | 2 | 2 | 2 | 9 | 5 | 8 | 10 | 6 | 6 | 1 | 5 | – | – | – | 7 | 13 | 13 | 10 | 20 | 12 |
| Golgi | 13 | 34 | 13 | 10 | 10 | 17 | 30 | 17 | 9 | 13 | 5 | 19 | 24 | 44 | 35 | – | – | – | 5 | 10 | 3 | 2 | 6 | 3 |
| Mitochondria | 66 | 10 | 4 | 10 | 4 | 42 | 39 | 45 | 79 | 84 | 92 | 76 | 2 | 3 | 1 | – | – | – | 9 | 6 | 11 | 5 | 10 | 8 |
| Nucleus | 1 | 0 | 2 | 1 | 0 | 1 | 1 | 0 | 0 | 0 | 0 | 1 | 0 | 1 | 2 | – | – | – | 0 | 0 | 0 | 1 | 1 | 0 |
| Nuclear Periphery | 3 | 0 | 0 | 0 | 0 | 0 | 0 | 0 | 2 | 0 | 1 | 0 | 0 | 0 | 0 | – | – | – | 0 | 0 | 0 | 0 | 0 | 1 |
| Nucleolus | 0 | 0 | 0 | 1 | 0 | 0 | 2 | 7 | 0 | 2 | 1 | 0 | 0 | 0 | 0 | – | – | – | 0 | 0 | 0 | 0 | 0 | 0 |
| Peroxisomes | 62 | 18 | 10 | 32 | 11 | 23 | 11 | 6 | 4 | 14 | 7 | 5 | 32 | 36 | 27 | – | – | – | 17 | 4 | 7 | 4 | 2 | 10 |
| SpindlePole | 4 | 5 | 2 | 9 | 5 | 2 | 4 | 7 | 0 | 3 | 1 | 1 | 9 | 10 | 9 | – | – | – | 1 | 0 | 0 | 2 | 2 | 1 |
| Vac/Vac Membrane | 1 | 1 | 1 | 3 | 1 | 2 | 4 | 15 | 7 | 7 | 2 | 3 | 1 | 2 | 1 | – | – | – | 2 | 2 | 1 | 2 | 2 | 5 |
| Unique Cell Count | 295 | 213 | 108 | 129 | 138 | 216 | 221 | 274 | 133 | 209 | 139 | 166 | 227 | 282 | 310 | 329 | 263 | 153 | 230 | 382 | 450 | |||
| Labelled Cell Count | 507 | 331 | 159 | 216 | 200 | 324 | 347 | 379 | 187 | 317 | 202 | 259 | 352 | 440 | 452 | 329 | 263 | 153 | 230 | 382 | 450 | |||
Yeast GFP Assignment
Protein Abundance
| Screen | WT1 | WT2 | WT3 | RAP60 | RAP140 | RAP220 | RAP300 | RAP380 | RAP460 | RAP540 | RAP620 | RAP700 | HU80 | HU120 | HU160 | rpd3Δ_1 | rpd3Δ_2 | rpd3Δ_3 | AF100 | AF140 | AF180 |
|---|---|---|---|---|---|---|---|---|---|---|---|---|---|---|---|---|---|---|---|---|---|
| Mean Cell GFP Intensity (1e-4) | 7.4 | 9.9 | 8.9 | 9.1 | 9.6 | 8.1 | 8.4 | 8.6 | 7.1 | 7.5 | 7.0 | 7.3 | 10.1 | 10.3 | 9.6 | – | – | – | 9.3 | 9.2 | 9.5 |
| Std Deviation (1e-4) | 1.1 | 1.8 | 1.5 | 2.0 | 1.9 | 1.6 | 1.6 | 1.6 | 1.6 | 1.5 | 2.1 | 1.4 | 1.6 | 1.7 | 1.6 | – | – | – | 1.5 | 1.4 | 1.5 |
| Intensity Change (Log2) | – | – | – | 0.04 | 0.11 | -0.12 | -0.08 | -0.05 | -0.31 | -0.23 | -0.35 | -0.29 | 0.19 | 0.22 | 0.12 | – | – | – | 0.07 | 0.06 | 0.1 |
Localization Change
| Localization | RAP60 | RAP140 | RAP220 | RAP300 | RAP380 | RAP460 | RAP540 | RAP620 | RAP700 | HU80 | HU120 | HU160 | rpd3Δ_1 | rpd3Δ_2 | rpd3Δ_3 |
|---|---|---|---|---|---|---|---|---|---|---|---|---|---|---|---|
| Cortical Patches | 0 | -1.3 | -1.1 | -2.3 | -3.3 | -5.6 | -4.3 | -6.6 | -2.6 | 0.2 | -0.2 | -2.0 | – | – | – |
| Bud | 1.8 | 1.3 | 0.7 | 1.5 | 0.9 | -0.3 | 1.6 | 0.3 | 0.3 | 0.9 | 0.5 | 0 | – | – | – |
| Bud Neck | 0 | 0 | 0 | 0 | 0 | 0 | 0 | 0 | 0 | 0 | 0 | 0 | – | – | – |
| Bud Site | 0 | 0 | 0 | 0 | 0 | 0 | 0 | 0 | 0 | 0 | 0 | 0 | – | – | – |
| Cell Periphery | -0.4 | 0.3 | 0.7 | -0.7 | -0.9 | 0 | 0.1 | -1.9 | -2.0 | 0.4 | 2.1 | 1.4 | – | – | – |
| Cytoplasm | -1.8 | 1.9 | -2.4 | -0.7 | -0.1 | -2.3 | -1.6 | -1.7 | -2.7 | 0.6 | -0.4 | 1.9 | – | – | – |
| Endoplasmic Reticulum | -0.2 | -0.6 | 1.5 | 3.0 | 1.3 | 1.1 | 0.5 | 0.5 | 1.7 | 0.1 | 0.4 | 1.3 | – | – | – |
| Endosome | 0 | 0 | 0 | 0 | 0 | 0 | 0 | 0.8 | 0 | 0 | 0 | 0 | – | – | – |
| Golgi | -1.1 | -1.3 | -1.2 | 0.4 | -1.9 | -1.4 | -1.8 | -2.5 | -0.1 | -0.4 | 0.9 | -0.2 | – | – | – |
| Mitochondria | 1.3 | 0 | 3.8 | 3.5 | 3.3 | 9.0 | 6.9 | 10.0 | 7.5 | 0 | 0 | 0 | – | – | – |
| Nucleus | 0 | 0 | 0 | 0 | 0 | 0 | 0 | 0 | 0 | 0 | 0 | 0 | – | – | – |
| Nuclear Periphery | 0 | 0 | 0 | 0 | 0 | 0 | 0 | 0 | 0 | 0 | 0 | 0 | – | – | – |
| Nucleolus | 0 | 0 | 0 | 0 | 0 | 0 | 0 | 0 | 0 | 0 | 0 | 0 | – | – | – |
| Peroxisomes | 3.1 | -0.4 | 0.4 | -1.5 | 0 | -2.1 | -0.8 | -1.3 | -2.2 | 1.2 | 1.0 | -0.2 | – | – | – |
| SpindlePole | 1.9 | 0 | 0 | 0 | 0 | 0 | 0 | 0 | 0 | 0 | 0 | 0 | – | – | – |
| Vacuole | 0 | 0 | 0 | 0 | 0 | 0 | 0 | 0 | 0 | 0 | 0 | 0 | – | – | – |
External localization resources
Images






























Protein Concentration and Protein Localization Data
| R1 | R2 | R3 | ||||||||||||||||
|---|---|---|---|---|---|---|---|---|---|---|---|---|---|---|---|---|---|---|
| G1 Pre-START | G1 Post-START | S/G2 | Metaphase | Anaphase | Telophase | G1 Pre-START | G1 Post-START | S/G2 | Metaphase | Anaphase | Telophase | G1 Pre-START | G1 Post-START | S/G2 | Metaphase | Anaphase | Telophase | |
| Concentration | 2.5051 | 3.016 | 2.9681 | 3.122 | 2.2928 | 2.7506 | 2.9717 | 3.6646 | 3.5711 | 3.0899 | 2.7715 | 3.4586 | 3.8796 | 4.2056 | 4.4034 | 4.3832 | 4.1683 | 4.2539 |
| Actin | 0.7981 | 0.6189 | 0.7906 | 0.7433 | 0.6287 | 0.7376 | 0.7138 | 0.6417 | 0.7546 | 0.702 | 0.7535 | 0.8601 | 0.8154 | 0.6348 | 0.7946 | 0.811 | 0.735 | 0.858 |
| Bud | 0.0082 | 0.0132 | 0.0322 | 0.024 | 0.0145 | 0.0015 | 0.0065 | 0.0073 | 0.0366 | 0.0209 | 0.0094 | 0.0034 | 0.0018 | 0.0161 | 0.0227 | 0.0144 | 0.0114 | 0.0009 |
| Bud Neck | 0.0065 | 0.0044 | 0.0138 | 0.0035 | 0.0015 | 0.1035 | 0.0189 | 0.0083 | 0.0128 | 0.018 | 0.0042 | 0.0612 | 0.0048 | 0.004 | 0.0165 | 0.0123 | 0.0158 | 0.0637 |
| Bud Periphery | 0.0078 | 0.012 | 0.056 | 0.0564 | 0.0593 | 0.0028 | 0.0106 | 0.0066 | 0.0647 | 0.0663 | 0.0085 | 0.0081 | 0.0025 | 0.0156 | 0.0398 | 0.0157 | 0.0101 | 0.001 |
| Bud Site | 0.0139 | 0.0801 | 0.031 | 0.0104 | 0.0026 | 0.0018 | 0.0614 | 0.2161 | 0.0527 | 0.0259 | 0.0059 | 0.0065 | 0.0175 | 0.1268 | 0.0386 | 0.0181 | 0.0057 | 0.0012 |
| Cell Periphery | 0.001 | 0.0012 | 0.0006 | 0.001 | 0.0007 | 0.0006 | 0.001 | 0.0014 | 0.0011 | 0.0013 | 0.0002 | 0.0007 | 0.0003 | 0.001 | 0.0004 | 0.0003 | 0.0009 | 0.0002 |
| Cytoplasm | 0.0345 | 0.0748 | 0.0158 | 0.0366 | 0.0456 | 0.0183 | 0.0086 | 0.0375 | 0.0235 | 0.0095 | 0.0856 | 0.0088 | 0.0045 | 0.0907 | 0.023 | 0.0117 | 0.0574 | 0.0095 |
| Cytoplasmic Foci | 0.0232 | 0.0873 | 0.0098 | 0.0124 | 0.0651 | 0.0215 | 0.0414 | 0.0313 | 0.0095 | 0.0362 | 0.0271 | 0.0129 | 0.0317 | 0.0479 | 0.0214 | 0.0346 | 0.0754 | 0.0208 |
| Eisosomes | 0.0008 | 0.0014 | 0.0004 | 0.0005 | 0.0003 | 0.0007 | 0.0013 | 0.0011 | 0.0003 | 0.0005 | 0.0003 | 0.0006 | 0.0005 | 0.0002 | 0.0003 | 0.0003 | 0.0002 | 0.0005 |
| Endoplasmic Reticulum | 0.0077 | 0.0014 | 0.0005 | 0.0012 | 0.0005 | 0.0018 | 0.0011 | 0.0003 | 0.0004 | 0.0007 | 0.0045 | 0.0009 | 0.0037 | 0.0008 | 0.0002 | 0.0016 | 0.0009 | 0.0004 |
| Endosome | 0.0211 | 0.0204 | 0.015 | 0.0328 | 0.022 | 0.0264 | 0.0123 | 0.0032 | 0.0083 | 0.0249 | 0.0244 | 0.0054 | 0.0227 | 0.011 | 0.0076 | 0.0265 | 0.0343 | 0.0072 |
| Golgi | 0.0328 | 0.0295 | 0.0155 | 0.0233 | 0.0404 | 0.026 | 0.0115 | 0.0055 | 0.0092 | 0.0127 | 0.0249 | 0.0078 | 0.0202 | 0.018 | 0.0115 | 0.0203 | 0.0268 | 0.0124 |
| Lipid Particles | 0.0092 | 0.0032 | 0.0025 | 0.0116 | 0.0085 | 0.006 | 0.006 | 0.0008 | 0.0007 | 0.0124 | 0.0017 | 0.0005 | 0.0082 | 0.0005 | 0.0026 | 0.0014 | 0.0027 | 0.0014 |
| Mitochondria | 0.0081 | 0.0132 | 0.0056 | 0.0081 | 0.0722 | 0.0097 | 0.0442 | 0.0006 | 0.0015 | 0.005 | 0.0038 | 0.0018 | 0.0031 | 0.0016 | 0.0024 | 0.0032 | 0.0033 | 0.0012 |
| None | 0.0012 | 0.0072 | 0.0005 | 0.0014 | 0.0005 | 0.0013 | 0.0052 | 0.0092 | 0.0055 | 0.0036 | 0.0169 | 0.0005 | 0.0071 | 0.0007 | 0.0002 | 0.0008 | 0.0017 | 0.0008 |
| Nuclear Periphery | 0.0023 | 0.0004 | 0.0005 | 0.0006 | 0.0003 | 0.0018 | 0.0028 | 0.0001 | 0.0059 | 0.0068 | 0.0017 | 0.0001 | 0.0132 | 0.0001 | 0.0001 | 0.0034 | 0.0002 | 0.0008 |
| Nucleolus | 0.0001 | 0.0002 | 0.0003 | 0.0014 | 0.0001 | 0.0024 | 0.0037 | 0.0001 | 0.0001 | 0.0151 | 0 | 0 | 0.0005 | 0.0002 | 0.0001 | 0.0001 | 0.0002 | 0.0001 |
| Nucleus | 0.0003 | 0.0003 | 0.0004 | 0.0008 | 0.0003 | 0.0054 | 0.0053 | 0.0002 | 0.0005 | 0.0102 | 0.0007 | 0.0001 | 0.0015 | 0.0004 | 0.0001 | 0.0014 | 0.0003 | 0.0003 |
| Peroxisomes | 0.0195 | 0.0287 | 0.0076 | 0.0128 | 0.0344 | 0.0241 | 0.0327 | 0.0279 | 0.0107 | 0.0118 | 0.0247 | 0.02 | 0.0334 | 0.028 | 0.0168 | 0.0191 | 0.0135 | 0.0178 |
| Punctate Nuclear | 0.001 | 0.0012 | 0.0006 | 0.0004 | 0.0011 | 0.0004 | 0.0059 | 0.0003 | 0.0007 | 0.0093 | 0.0006 | 0.0002 | 0.005 | 0.0004 | 0.0005 | 0.0019 | 0.0015 | 0.0015 |
| Vacuole | 0.0019 | 0.0007 | 0.0007 | 0.0147 | 0.0009 | 0.0045 | 0.005 | 0.0005 | 0.0005 | 0.0058 | 0.0008 | 0.0002 | 0.0014 | 0.0008 | 0.0005 | 0.0013 | 0.0016 | 0.0002 |
| Vacuole Periphery | 0.0009 | 0.0002 | 0.0002 | 0.0026 | 0.0006 | 0.0019 | 0.001 | 0 | 0.0002 | 0.0012 | 0.0005 | 0.0001 | 0.0009 | 0.0002 | 0.0001 | 0.0007 | 0.0011 | 0.0001 |
Sequencing Data
| R1 | R2 | |||||||||
|---|---|---|---|---|---|---|---|---|---|---|
| G1 Post-START | S/G2 | Metaphase | Anaphase | Telophase | G1 Post-START | S/G2 | Metaphase | Anaphase | Telophase | |
| Gene Expression | 23.258 | 19.8242 | 17.222 | 22.2559 | 24.1942 | 24.3263 | 31.8997 | 30.1917 | 31.6058 | 24.2989 |
| Translational Efficiency | 1.8936 | 1.764 | 1.7028 | 1.8439 | 1.4153 | 1.9851 | 0.9703 | 1.22 | 1.2178 | 1.371 |
Hit Data
| Dataset | Hit |
|---|---|
| Protein Concentration | ✘ |
| Protein Localization | ✘ |
| Gene Expression | ✘ |
| Translational Efficiency | ✘ |
Endocytosis
| Temp | Actin Patch (Sac6-tdTomato) | Cortical Patch (Sla1-GFP) | Late Endosome (Snf7-GFP) | Vacuole (Vph1-GFP) |
|---|---|---|---|---|
| 37℃ | ||||
| RT |
Cell Cycle Omics
CYCLoPs (Aim21-GFP)
| Gene / Allele | Actin Patch (Sac6-tdTomato) | Cortical Patch (Sla1-GFP) | Late Endosome (Snf7-GFP) | Vacuole (Sac6-tdTomato) |
|---|
| Gene | Images |
|---|
| Gene | Images |
|---|
Images are not yet available
Images are not yet available